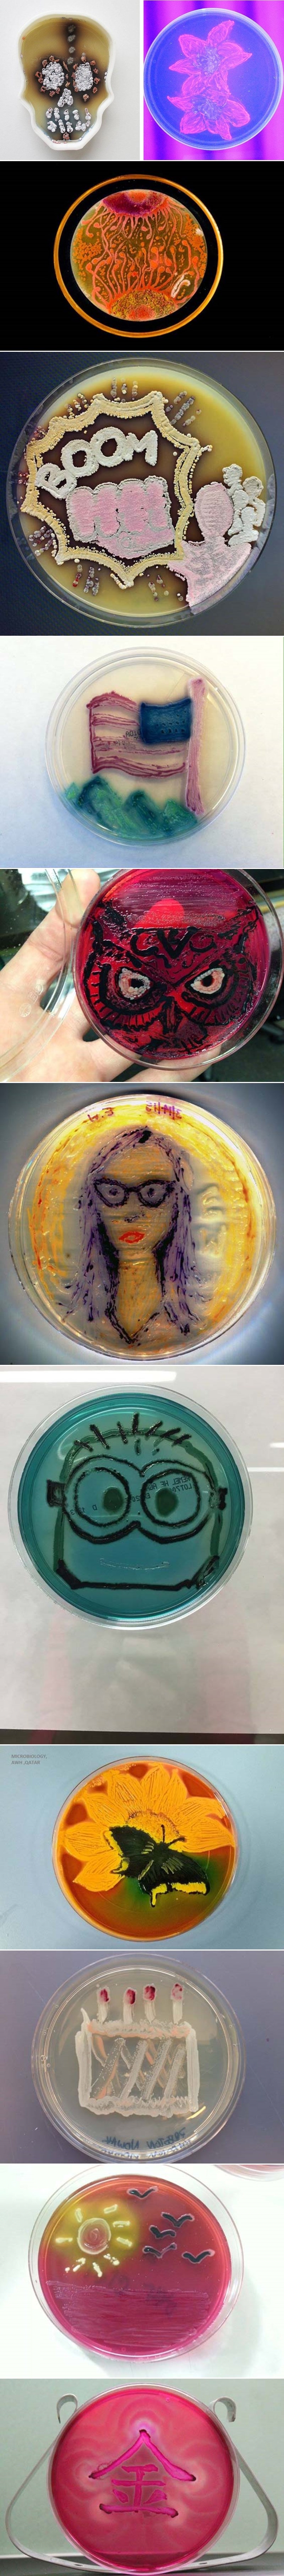
Otkrijte čudesan šareni svijet slikanja bakterijama

Kreativno
• 23 kolovoza 2016
Otkrijte čudesan šareni svijet slikanja bakterijama
5K
Dobrodošli u mikrobiološku umjetnost - umjetnici pomoću različitih sojeva bakterija na hranjivoj podlozi stvaraju prave male slikarije. Pravo slikarsko "podzemlje".
Radovi su nastali za Agar Art Contest, kojeg vodi Američko udruženje mikrobiologa, a za natjecanje je bilo potrebno otkriti ljepotu ovog nevidljivog svijeta koristeći Petrijeve zdjelice umjesto platna. Rezultati su blago odvratni i iznenađujuće puni boje.
Ipak, malo upozorenje: ako primjetite nešto slično na večeri od jučer, bolje bacite u smeće.
Radovi su nastali za Agar Art Contest, kojeg vodi Američko udruženje mikrobiologa, a za natjecanje je bilo potrebno otkriti ljepotu ovog nevidljivog svijeta koristeći Petrijeve zdjelice umjesto platna. Rezultati su blago odvratni i iznenađujuće puni boje.
Ipak, malo upozorenje: ako primjetite nešto slično na večeri od jučer, bolje bacite u smeće.

















